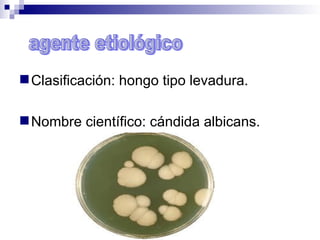
Clasificación: hongo tipo levadura.
Nombre científico: cándida albicans.

Incrustar presentación









La candidiasis es una infección causada por el hongo Candida albicans que se encuentra de forma natural en el cuerpo humano. Afecta principalmente la vagina, boca y esófago, causando síntomas como picor, dolor, flujo vaginal o prurito al orinar. Se trata generalmente con antifúngicos como el clotrimazol y evitando la humedad excesiva y manteniendo una buena higiene.